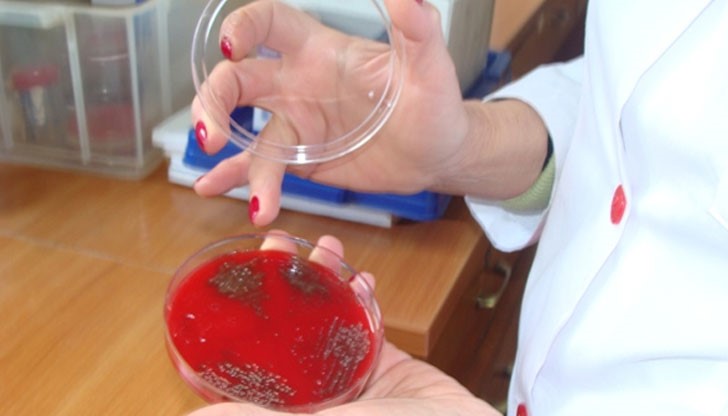
10 първокласници и учителка от СОУ "Васил Левски" в Русе се лекуват от салмонела вкъщи

Децата носители на салмонела са изолирани
- Редактор: Виктор Тошев
- Коментари: 0
10 първокласници и учителка от СОУ "Васил Левски" в Русе се лекуват от салмонела вкъщи, съобщиха от училището.
Децата са изолирани като носители на бактерите, но не са болни. От Регионалната здравна инспекция /РЗИ/ изследват взетите лабораторни проби, за да открият причината за заразата, предаде вестник Труд.
Резултатите трябва да станат ясни до края на седмицата. Предполага се, че салмонелата е прихваната от лекувано дете в инфекциозното отделение на МБАЛ - Русе след престой на село. То е изписано като напълно здраво. В училището се поддържа добра хигиена, а храната се доставя от фирма за кетъринг. В нея не са открити болестни бактерии.






















Асен Генов: Оставката на Борислав Сарафов отприщва ново...
Кабинетът актуализира таксите за новите лични документи
Асен Генов: Оставката на Борислав Сарафов отприщва ново...
Връчиха немските езикови дипломи на випуск 2026 в „Дойче...
Асен Генов: Оставката на Борислав Сарафов отприщва ново...